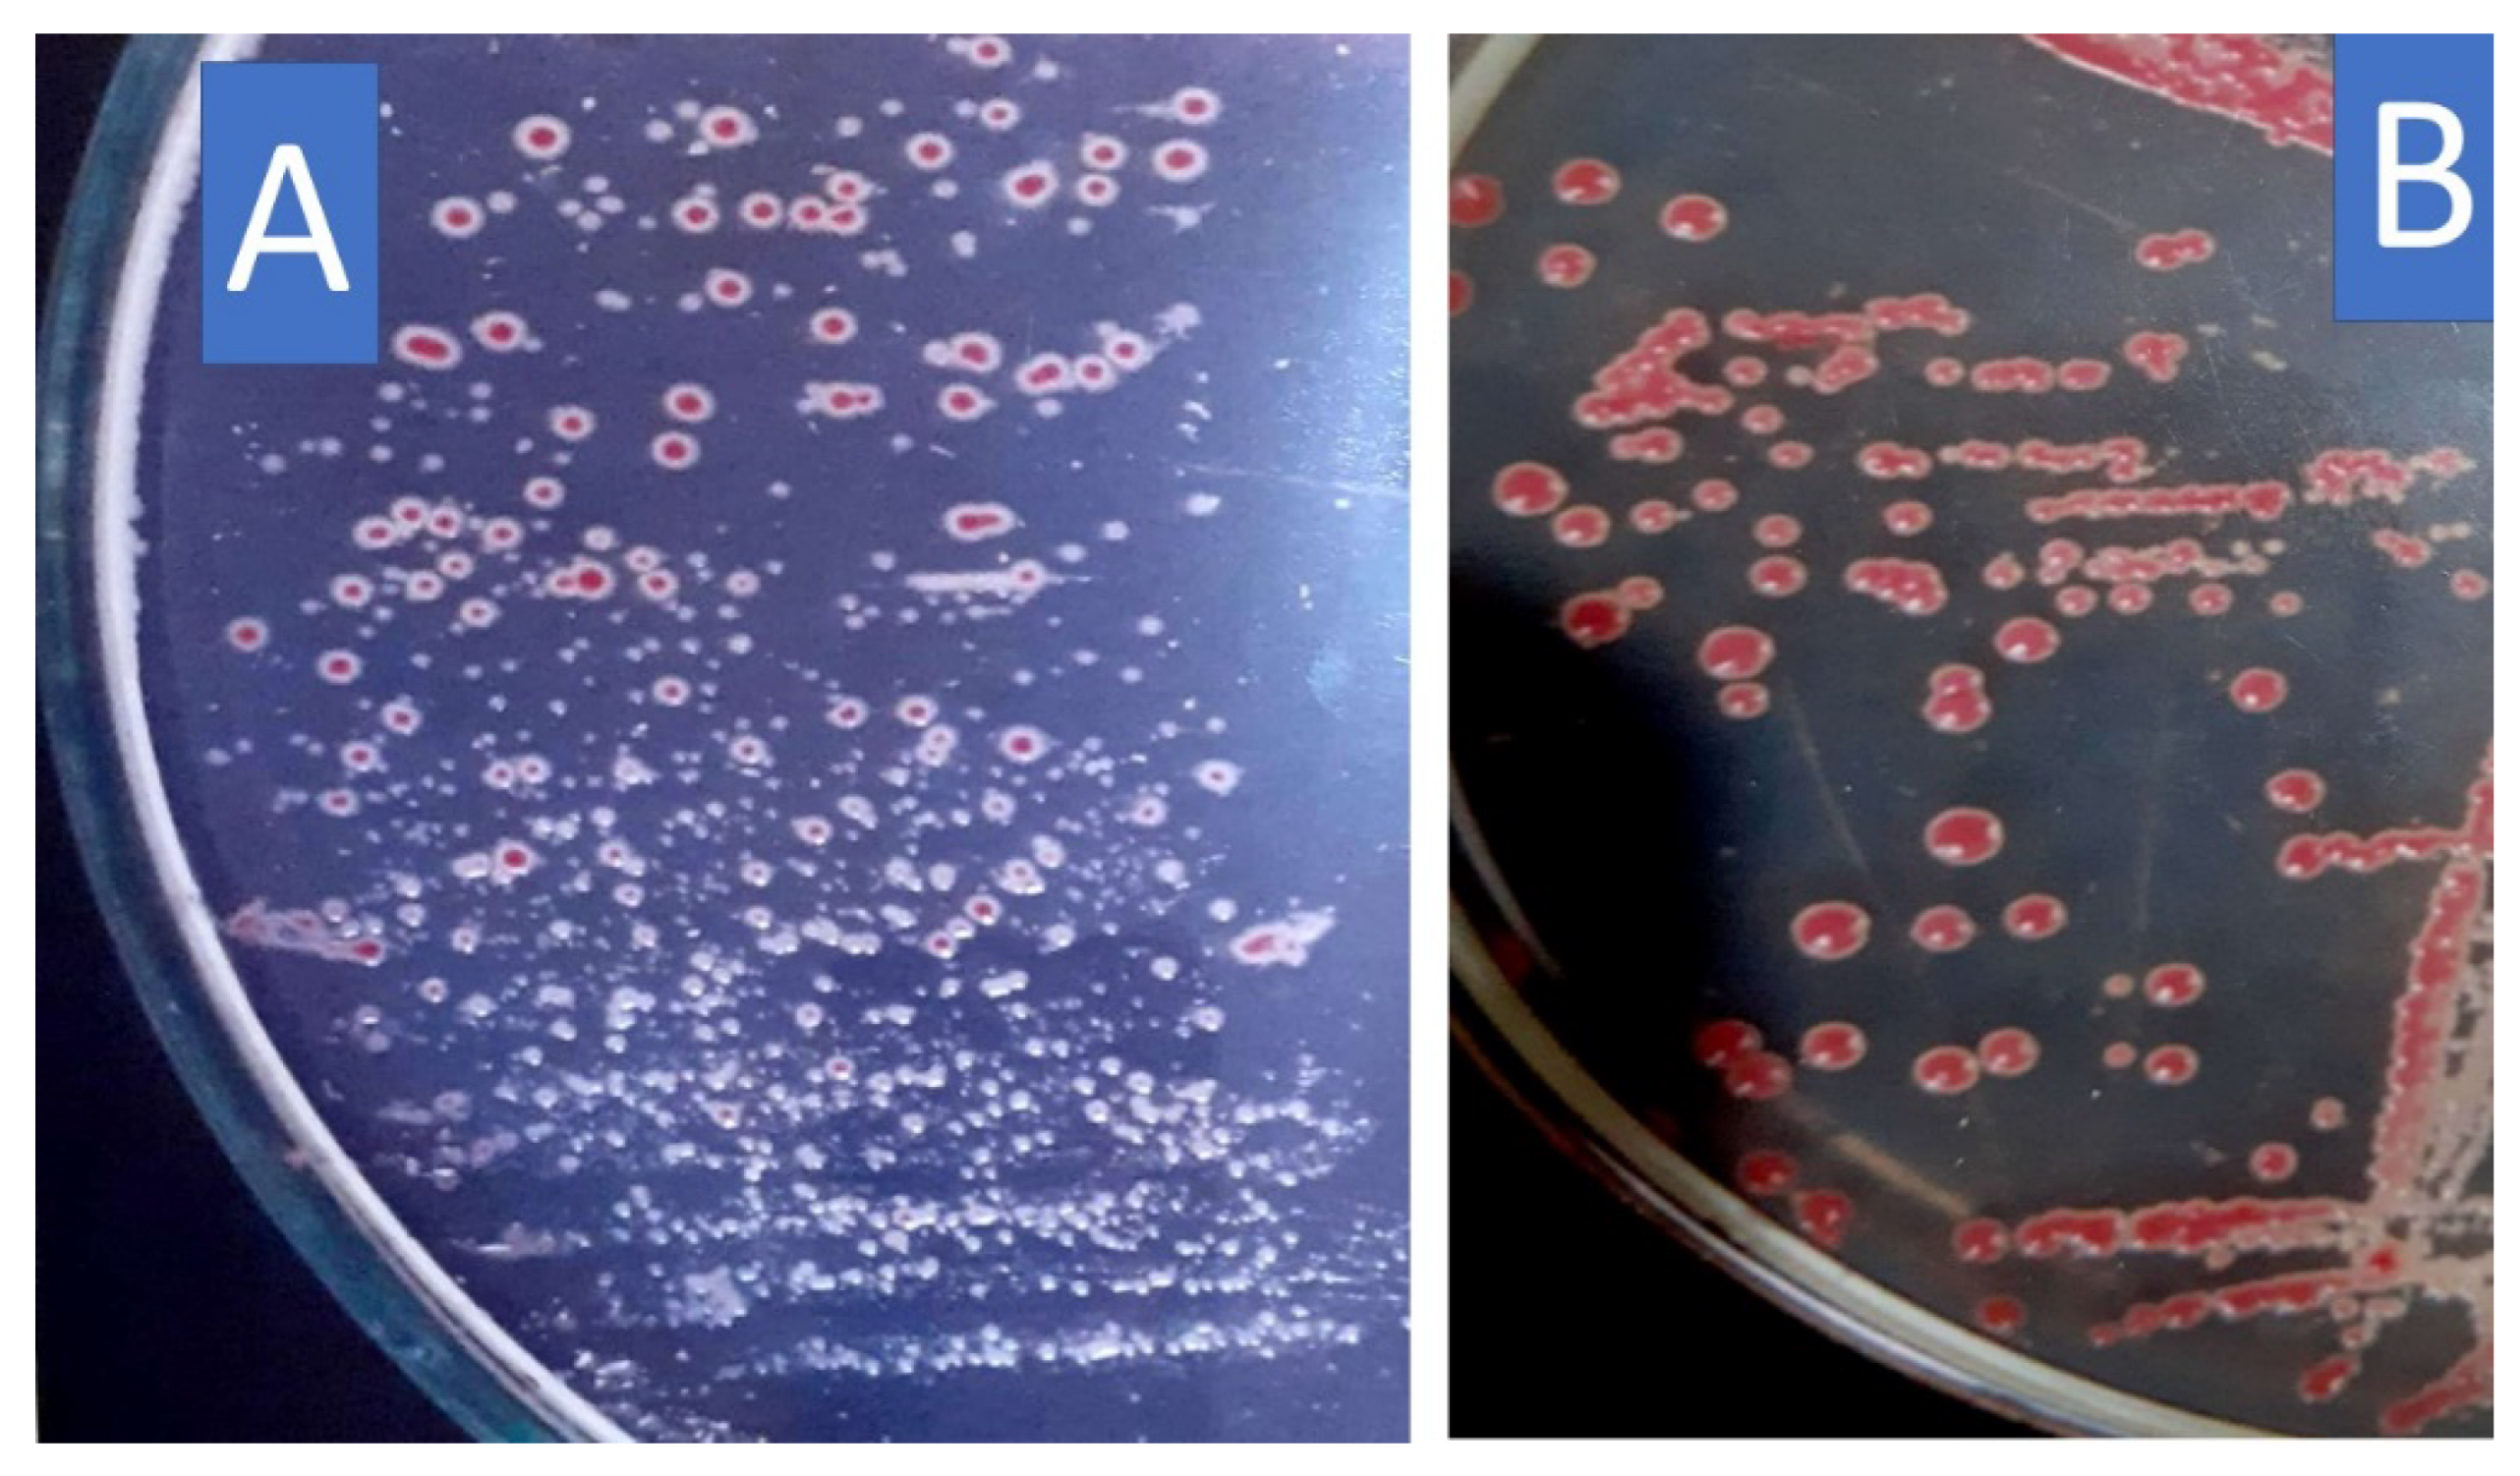
Microorganisms 10 01814 g001

1. Introduction
Ralstonia solanacearum is a unique, important worldwide bacterial plant pathogen according to its economic and scientific value [
1], representing the causative pathogen of wilt disease in about 250 species, including essential economic crops, e.g., potato, tomato, banana, and peanut [
2]. Potato wilt (brown rot) generated by
R. solanacearum is a serious disease worldwide, leading to severe yield losses, reaching up to 100% in Kenya [
3] and up to 75% in Australia [
4]. In Egypt, bacterial wilt was announced many years ago as the most significant bacterial disease on potatoes [
5]. The accumulation of bacterial cells, together with the slimy exopolysaccharides, and virulence-related factors lead to blocking the vessels, consequently stopping the sap flow, which in turn, generates the wilt disease [
6]. Many chemical, biological, and physical tools were used to control this bacterium. Biological control agents are hopeful eco-friendly tools alternative to pesticides to manage plant diseases that are beneficial in protecting crop plants and safeguarding food as well [
7].
The use of the avirulent
R. solanacearum strain to manage the virulent strain is one of the promising biocontrol strategies [
8]. However, studies in such areas are still lacking the best application method. An avirulent strain did not antagonize the virulent strain and was not bacteriocinogenic, but can reduce the disease severity by up to 50% [
9,
10]. For instance, the bacteriocinogenic avirulent strain of
R. solanacearum was effectively controlled on tobacco [
11] and tomato [
12] bacterial wilt. While, on the opposite side, other studies revealed that the avirulent strains of
R. solanacearum have an antagonistic action versus the virulent
R. solanacearum strain in vitro and in vivo [
9,
10]. Furthermore, the avirulent strain of
R. solanacearum can be used solely or in a recipe with other factors to constrain bacterial wilt disease [
13,
14].
Extracellular polysaccharides secreted by
R. solanacearum were used as a specific elicitor of defense responses against bacterial wilt disease of tomato [
15]. Many factors play roles in the virulence of
R. solanacearum, in particular the secretion system effectors (type II and III), N-acetylated extracellular polysaccharide I, and twitching and/or swimming motility (type IV pili-driven twitching and flagella-swimming motility), and cell-wall-degrading enzymes [
16].
The bacterial supernatant can be used to manage wilt in potato plants, in this respect, the supernatant of
Saccharomyces cerevisiae drastically lessened the disease rate of bacterial wilt disease [
17]. The virulent strain of
R. solanacearum may spontaneously convert to an avirulent strain in vitro and in vivo. On the opposite side, the reversal mutation of the avirulent strain into a virulent one has recently been reported [
6,
18]. On such a basis, the use of supernatant for the avirulent strain of
R. solanacearum may represent suitable protection against the virulent strain.
The virulent supernatant of microorganisms can be used to control diseases after thermal treatment, unfortunately, the temperature has a huge destroying effect on the cell structure and physiology, however, membranes, proteins, enzymes, DNA, and RNA are also affected [
19]. The boiling process of the microbial supernatant led to the breaking of some compounds and/or reactions between different components present in the supernatants [
20,
21]. The high temperature also led to damage and alteration of the bacterial cell membrane and its components [
19]. Therefore, the avirulent strains could be applied as a safe protection agent, without prior treatment.
This study aimed to manage the wilt disease of potatoes, caused by the virulent R. solanacearum, using the supernatant and/or cells of an avirulent strain of the same bacterium. According to the authors’ knowledge, there is no preceding trial that uses bacterial supernatant or dead cells of an avirulent R. solanacearum in the biocontrol of the virulent strain of bacterial wilt disease, therefore, this study is considered a pioneer in this area.
2. Materials and Methods
All chemicals and components of the used media were purchased from Sigma-Aldrich Company (Sigma-Aldrich, Inc., St. Louis, MO, USA).
2.1. Bacterial Pathogen
Potato tubers displaying distinctive symptoms of brown rot were washed with sterilized tap water and dried with filter paper, and then surface sterilization was performed using 2% sodium hypochlorite, and rinsing three times with sterile tap water. The bacterial isolation was carried out by transferring a loopful of bacterial ooze from an infected sterilized potato, onto the triphenyl tetrazolium chloride agar medium (TTC) [
22], and then incubated for 48 h at 28 ± 2 °C. The grown colony was picked up and re-streaked onto plates of the same medium to obtain pure cultures of the colonies. Bacterial isolate with a white appearance and a red center is regarded as virulent as
R. solanacearum, which was later identified according to morphological, biochemical, and physiological examinations [
23,
24]. The isolated pathogen was also molecularly identified.
2.2. Molecular Identification
DNA was extracted by centrifugation (8000×
g for 2 min) of one mL cell suspension, by washing the cells twice with 400 µL of STE Buffer (100 mM NaCl, 10 mM Tris/HCl, 1 mM EDTA, pH 8.0), and centrifuged (8000×
g for 2 min), and then resuspended in 200 µL TE buffer (10 mM Tris/HCl, 1 mM EDTA, pH 8.0), and 100 µL Tris-saturated phenol (pH 8.0) was added to the tube, and vortexed (60 s) for lysing bacterial cells. Finally, the aqueous phase was separated from the organic one by centrifugation (4 °C, for 5 min at 13,000×
g). The aqueous upper phase (160 µL) was transferred to a 1.5 mL tube, to which TE buffer (40 µL) was added followed by chloroform (100 µL) and centrifuged (4 °C, for 5 min at 13,000×
g) [
25].
For 16S ribosomal RNA analysis, PCR amplification mixture contained 1× reaction buffer, 1.5 mM MgCl2, 1U Taq DNA polymerase (Promega), 2.5 mM dNTPs, 30 poml of individual primer, and 30 ng genomic DNA. The primer codes were 27F (5′-AGAGTTTGATCCTGGCTAG-3′), and 1492R (5′-GGTTACCTTGTTACGACTT-3′) with a product size of 1500 bp. The thermo-cycling program was completed in a Perkin-Elmer/GeneAmp® PCR System 9700 (PE Applied Biosystems, Waltham, MA, USA) automated to an initial denaturation cycle (5 min at 94 °C). Followed by 40 cycles, each cycle involved denaturation (30 s at 94 °C), annealing (30 s at 45 °C), and elongation (1 min at 72 °C) steps. The extension segment of the primer stretched to 7 min at 72 °C in the final cycle.
In the detection of the PCR, the amplification outcome was determined by electrophoresis (1.5% agarose gel, including 0.5 µg/mL ethidium bromide in 1X TBE buffer) at 95 volts. A DNA ladder (100 bp) was utilized as a molecular standard. Visualization, and photographing of PCR segments in the UV light as accomplished by Gel Documentation System (BIO-RAD 2000).
The reaction for purification of the amplified PCR was carried out in a 1.5 mL microfuge tube containing the amplified PCR and three volumes of binding buffer 1. The mixture was transferred to the EZ-10 spin column and left (2 min) at room temperature, the column was then washed (750 µL of wash solution), and centrifugated (10,000 rpm for two min), the latter process was repeated to eliminate any residual of wash solution. Then, elution buffer (50 µL) was added and incubated at room temperature (2 min), and the purified DNA was stored (−20 °C).
The PCR sequencing process was performed, following the protocols supplied with the automatic sequencer ABI PRISM 3730XL Analyzer using Big Dye TM Terminator Cycle Sequencing Kits. Rbcl forward primer was applied to perform single-pass sequencing. The ethanol precipitation protocol was applied to purify fluorescent-labeled fragments from the unincorporated terminators and then resuspended in distilled water for electrophoresis (ABI 3730xl sequencer, Microgen Company). The sequence was investigated computationally utilizing the BLAST program (
http://www.ncbi.nlm.nih.gov/BLAST (accessed on 14 Jule 2022)), and aligned by Align Sequences Nucleotide BLAST.
2.3. Avirulent R. solanacearum
To obtain avirulent strain, the virulent strain was stored on the nutrient glucose agar (NGA) slant and kept for 3 weeks, and then streaked onto TTC plates and checked for the development of the avirulent type that has deep red colonies. Both strains were propagated onto NGA plates and incubated at 28 ± 2 °C for 48 h. For storage of the two strains, a loopful of each strain was transferred to a screw test tube containing sterilized tap water and kept at room temperature [
26].
2.4. Lytic Activity of Bacterial Strains
2.4.1. Culturing Technique
The two bacterial strains were screened for the production of lytic enzymes in a nutrient glucose broth medium. The flasks were injected with 1.0 mL of bacteria inoculum (108 cfu/mL). The inoculum was prepared from a 2-day-old culture. After incubation (3 days at 30 °C), the supernatant was then separated through centrifugation (5000 rpm for 20 min). The resulting supernatant was examined for lytic activity.
2.4.2. Assay of Hydrolytic Enzymes
Xylanase and filter paperase (FPase) were assayed in the cultural supernatant, xylan, and microcrystalline cellulose, correspondingly, served as substrates. The substrates (0.5%) were solely mixed in 0.05 M citrate buffer (pH 4.8). The supernatant and substrate-buffer solution were mixed (1:1
v/v), and incubated for 30 (xylanase), and 60 min (Fpase), at 50 °C. The activity of α-amylase and polygalacturonases (PGase) were detected in the same way, using 1% soluble starch (in citrate phosphate buffer pH 6.6), and 1% pectin (in 0.1 M sodium acetate buffer, pH 5.2), respectively, after incubated for 30 min at 40 °C. The released reducing groups of the four enzymes were determined spectrophotometrically at A
575 with 3,5-dinitrosalicylic acid method [
27,
28,
29,
30]. The unit (U) of the enzyme was expressed as the quantity of enzyme needed to release 1 µmol/g/min of reducing units of xylose (xylanase), glucose (Fpase, and α-amylase), or polygalacturonic acid (PGase) under the assay conditions.
Protease was measured in the bacterial supernatant utilizing casein as a substrate. The liberated amino acids after 10 min incubation at 37 °C were split by trichloroacetic acid and measured at A
280 [
31]. Protease U was described as the quantity of the lipase that liberates 1 µg tyrosine/g/min under the test conditions.
2.5. Dual Culture Technique
To discover the presence of any kind of antagonism between the virulent and avirulent
R. solanacearum strains, the antagonistic activity was conducted [
32] with some modifications. The avirulent isolate was inoculated on NGA plates at 3 cm from the plate edge against the virulent isolate of
R. solanacearum, and then incubated (28 ± 2 °C for three days). The plate was investigated for the presence of an antagonism region between the two bacterial isolates.
2.6. Preparation of Treatments
For soil infestation, the virulent strain was inoculated in NGB and incubated (28 ± 2 °C) under shaking (120 rpm, for 48 h). Bacterial cells were separated by centrifugation (10,000× g for 20 min) and washed two times with sterilized tap water, and then the bacterial cells were re-suspended in sterilized water, to a final count of 108 cfu mL−1 that was used for infestation of the soil in pots.
For the preparation of various treatments, virulent and avirulent isolates of R. solanacearum were inoculated in 250 mL NGB in 500 mL flasks. The cultures were incubated (28 ± 2 °C) under shaking (120 rpm, for 48 h). Half of the grown cultures of the two bacteria (virulent and avirulent culture) were boiled in a water bath (100 °C, for 20 min) to kill bacterial cells. The boiled culture was left to cool at room temperature. The boiled and the non-boiled cultures were centrifuged (10,000× g for 20 min). The supernatants of both cultures were separated and sterilized using DWK 47 mm filtering apparatus with fritted glass and a 500 mL funnel (United Scientific Supplies, Libertyville, IL, USA) and used in the cell-free extract treatments. The precipitated bacterial cells were washed as described above and resuspended in sterilized water to yield 108 cfu mL−1.
2.7. Pathogenicity and Virulence Tests on Tomato Plants
Pathogenicity tests and virulence capability tests were performed on tomato seedlings to test the ability of different virulent and avirulent strains to cause the welting symptoms. The tomato pot experiment was applied at TagElezz Research Station, Dakahlia Governorate, Egypt (30°57′25″ N; 31°35′54″ E) in plastic bags (35 cm in diameter) filled with 20 kg of steam sterilized silt clay soil (25% sand: 41.5% silt: 33% clay).
Tomato seedlings (
Solanum lycopersicum cv. Red gold) at the 3-leaf stage were inoculated with 100 μL each, just above cotyledons using a one ml insulin syringe. Six seedlings were used for each treatment. The various forms of virulent and avirulent strains were control (water), the whole culture, supernatant only, boiled of the whole culture, boiled supernatant only, and dead cells only. The wilting symptoms were observed for three weeks. Wilt symptom progress was recorded daily according to six disease rate classes, i.e., no wilt (0), one leaf wilted (1), two or more leaves wilted (2), all leaves except the tip wilted (3), hole plant wilted (4), and collapse, and death of the plant (5) [
33].
2.8. Potato Pots Experiment
Tubers of potato stock of cultivar Spunta (Agrico Co. the Netherlands), highly susceptible to bacterial wilt infection, were utilized in this investigation. The soil of the pot experiment was prepared as mentioned above. The experiment was initiated in the 2020 summer season. First, all pots were infested by mixing the upper layer of the soil with 100 mL of a virulent strain of R. solanacearum (108 cfu mL−1) and regularly irrigated with water for 48 h to facilitate the spreading of R. solanacearum. Potato tubers were surface sterilized in 2% sodium hypochlorite and then washed and left to dry. A sharp, clean knife was used to slice potato tubers into pieces of equal size (approx. 2 inches square, for each), containing at least 2 to 3 active eyes. The healthy potato pieces were soaked for 30 min just before planting in different treatments as follows; (1) soil-infection only (control), (2) the whole culture of the avirulent strain (AV), (3) boiling the whole culture of the avirulent strain (BAV), (4) supernatant of the avirulent only (SAV), (5) boiled of avirulent supernatant only (SBAV), (6) dead avirulent cells only (DCAV), (7) virulent supernatant only (SV), (8) boiled of the whole virulent culture (BV), (9) boiled of virulent supernatant only (SBV), and (10) dead virulent cells only (DCV). Two potato tuber pieces were planted deep-on in each bag and grown in a greenhouse (100 days at 22 °C and 34 °C). A completely randomized block design was applied.
2.8.1. Physiological Performance
Total phenol was determined after 40 days from planting with Folin–Ciocalteu reagent [
34]. A fresh weight of 0.05 g of shoot tissue was ground in 10-times the volume of ethanol (80%) using and mortar, and pestle then centrifuged (for 20 min at 10,000 rpm). The filtrate was kept and the residue was treated again with 5-times of ethanol (80%) and centrifuged. The filtrates were collected and evaporated to dryness. The deposit was liquified in distilled water (5 mL). The total phenol was detected in a reaction mixture composed of 0.2 mL plant filtrate, 2.8 mL of distilled, and 0.5 mL of Folin reagent. After 3 min, Na
2CO
3 solution (20%) was also mixed thoroughly with the contents, and then boiled (one min in a water bath), and cooled. The absorbance was detected at A
650 nm [
35].
2.8.2. Assay of Defense Enzymes
The defense-related enzymes were extracted from plant leaves in Tris-HCl buffer (0.05 mM, pH 8.4) containing 15 mM β-mercaptoethanol, using a homogenizer, followed by centrifugation (10,000 rpm for 20 min) at 4 °C [
36]. The supernatant was used for the estimation of enzymes.
The reaction mixture of polyphenol oxidase (PPO) is composed of plant extract, 0.2 M potassium phosphate buffer (pH 7), and catechol as a substrate (1:2:1,
v/v). The change in absorbance was spectrophotometrically measured at A
420 nm. The unit of the enzyme activity (U) was stated as ΔA
420 min/g fresh weight under the assay conditions [
37].
The assay mixture of peroxidase activity (POD) consisted of 0.5 mL of plant extract, 1 mL of phosphate buffer (pH 7.1), 0.5 mL of pyrogallol, and 0.5 mM of H
2O
2. The developed color as a result of the pyrogallol oxidation was measured spectrophotometrically. The unit of the enzyme activity (U) was stated as ΔA
470 min/g fresh weight under the assay conditions [
37].
2.8.3. Disease Rating
The symptoms of wilt severity on potato plants were rated daily and recorded based on the following scale; 0 = no symptoms, 1 = up to 25% wilt, 2 ≤ 25 to 50% wilt, 3 ≤ 50 to 75% wilt, and 4 ≤ 75 to 100% of the foliage wilted [
38].
2.8.4. Growth, and Yield
After 70 days from planting, the height, number of branches, and dry weight of shoot (60 °C till constant weight). At harvesting time, the number and weight of tubers were estimated.
The leaf area index (LAI) measurement was performed using the disk method. The total fresh weight of plant leaves was determined. The whole leaf area was estimated with known desk diameter, discarding all fractional disks, thus the leaf area/weight relationship was calculated [
39].
Latent tuber infection was examined for the resulting potato tubers from various pot experiments after storage (6 weeks) at room temperature to allow the symptom development, and facilitate the detection of latent tuber infection [
40]. Then, the tubers were cut to estimate the number of infected tubers, and the percentage of latent tuber infection was calculated.
2.9. Gas Chromatography–Mass Spectrometry (GC–MS)
Four treatments, SV, SAV, BSV, and BSAV were analyzed via GC–MS, using Agilent 6890 gas chromatograph (Agilent, Santa Clara, CA, USA) equipment with an Agilent mass spectrometric detector, with a direct capillary interface and fused silica capillary column PAS-5MS (30 m × 0.32 mm × 0.25 μm film thickness). Carrier gas (helium) was at 1 mL/min, pulsed split less mode. The solvent delay and the size of the injection were 3 min and 1 μL, respectively. The mass detector of the spectrophotometry was performed in electron ionization mode of 70 eV voltage over the range of 50 to 500 m/z. The temperature of the ion source and quadrupole1 were 230 °C and 150 °C, respectively, with an EM voltage of 1650 V. The programmed temperature was initiated at 90 °C (3 min) and then raised at 8 °C/min up to 280 °C. The temperature of the injector and detector were 250 and 280 °C, correspondingly. The mass spectral patterns of the compounds were recognized with WILEY/NIST mass spectral database.
2.10. Statistical Analysis
The treatments were performed in six replicates (each replica consists of 3 bags), applying the completely randomized block design. The data were statistically analyzed by one-way analysis of variance, followed by means comparison using Tukey’s HSD test (probability, p ≤ 0.05) with the aid of CoStat software (version 6.450, CoHort Software, USA).
4. Discussion
Isolation trials identified
R. solanacearum, which is a worldwide soil-borne pathogen that generates bacterial wilt disease, thus infecting a wide range of plants. Conventionally,
R. solanacearum could be distinguished by ooze-out, exudation, or bacterial streaming from infested parts of the plant. This bacterium has two phenotypes: virulent and avirulent. The virulence factor of this bacterium can be lost during storage and subculturing, i.e., phenotypic conversion from virulent to avirulent phenotype [
6]. Recently, the reversal of the phenotypic conversion from avirulent to virulent was also reported [
18].
The molecular identification was carried out with 16S rRNA. All bacteria contain a 16S rRNA gene of about 1500 bp. The gene contains sections of DNA sequence that are exclusive to specific species. The species of an unknown bacterium may be deduced from its unique sequence of rRNA genes. The pathogenic isolate was identified as
R. solanacearum, and the 16S rRNA sequencing was registered on the GenBank under the accession number OP180100. Molecular identification is usually performed because of its sensitivity and specificity for the rapid identification of various organisms [
41]. The sequence used for constructing the phylogeny is totally interpreted and firmly correlated with the other similar bacterial strains in the GenBank database.
Generally, the virulent and avirulent
R. solanacearum exhibited lytic activity. The virulent strain has a higher lytic activity than the avirulent one. However, the lytic activity of the phytopathogenic microorganisms was found to be linked to pathogenicity thus playing a fundamental task in disease progression, and further, could be utilized as a differentiating tool [
31].
Cellulose, starch, pectin, and protein are the main components of plant tissue. Such a structure restricts the invasion of phytopathogens. That is why lytic enzymes play an essential role in the pathogenesis process. Therefore, xylanase, FPase, amylase, and proteinase were measured since these enzymes are known as cell wall-degrading enzymes and are involved in the pathogenicity process to facilitate microbial penetration into plant tissue [
29,
42]. The great disparity in the enzymatic profile among the virulence and virulence strains may be due to genetic variation and ecological conditions.
Cellulose is degraded by the lytic activity of cellulase into a single monomer of glucose [
29,
31]. Pectin is decomposed of galacturonic acid monomers and catalyzed by PGase by cleaving the α-1,4-glycosidic bond [
30,
31]. Starch is decomposed by amylase, leading to the liberation of glucose units [
42]. Finally, the nitrogenous part of the plant is hydrolyzed by proteases into peptides and amino acids [
42]. The synergistic action of the enzymatic consortium causes the maceration of plant tissue, thus facilitating the infection by the pathogen, and therefore, may be essential for pathogenicity. Lytic enzymes represent an additional threat to plant infection. In summing up, the current pathogen has a complementary profile of lytic enzymes, capable of causing a serious infection.
Some studies investigated the use of the avirulent strain of fungal plant pathogens to control the corresponding diseases such as the use of the avirulent
Colletotrichum to induce systemic resistance in strawberries [
43]. Similarly, different investigations indicated that non-pathogenic Fusarium can be used for the biological control of many diseases that have developed by the pathogenic strains, the mode of action of this biocontrol may be antibiosis, plant growth promotion, and/or induced systemic resistance. Secondary metabolites of such fungi can be used for biological control [
44]. Additionally, the avirulent,
Fusarium oxysporum f. sp.
lycopersici, can reduce susceptibility to virulent strains by activating either I, I-2, or both resistance proteins upon recognition of Avr1 of the Avr2/Six5 pair, respectively [
45]. The current investigation reported the first use of a bacterial pathogen as an inducer of plant systemic resistance.
The current study reported negative antagonism between the virulent and the virulent
R. solanacearum, since the avirulent strain of
R. solanacearum did not antagonize the virulent strain and it does not perform bacteriocinogenic action [
46]. Therefore, the avirulent isolate of this study might not be bacteriocinogenic. Contrasting results found that the avirulent strain antagonized the virulent strain of
R. solanacearum [
10,
47]. Accordingly, the proposed mode of action of the current biocontrol activity is restricted to the induced systemic resistance of plants by the avirulent
R. solanacearum.
The virulence ability is generally or partially attributed to the presence of fatty acids. Besides playing an important role in intercellular communication signals, fatty acids play a vital role in motility, which is important in the virulence system. The linkage and arrangement of fatty acids to the membrane propose a mechanism of swarming through the control of membrane fluidity [
48]. For instance, palmitic acid and its derivatives were found and play a central task in the virulence of
R. solanacearum [
49,
50].
The main constituent of the avirulent
R. solanacearum is “2(3H)-Furanone, 5-methyl”, which was reported to play a vital role in antimicrobial activity against
R. solanacearum and numerous other plant pathogenic bacteria [
51]. Although there was no antagonism between the current virulent and avirulent
R. solanacearum, there is another advantage of using the avirulent strain in the management of other microbial pathogens through its butanal, 2-methyl, which was reported as a valuable constituent in the biological control of plant disease [
52].
The pathogenicity test and welting capability of R. solanacearum on tomato seedlings revealed that all the used forms of the virulent strain led to the spread of the wilting disease. The highest recorded disease rate was observed with the whole culture of the virulent strain, while only the boiled supernatant led to the lowest value of disease rate. All treatments showed an ability to affect the wilting disease, presumably due to the presence of several components of virulence factors, what is more, the virulence factors of the pathogenic bacterium are distributed between the bacterial cell and its secreted supernatant, consequently, the presence of both are complementary and required for the complete development of the welting symptoms and disease as well. According to our knowledge, the current work is the first comprehensive study that elucidates the occurrence of the virulence factor in R. solanacearum by using the virulent strain and/or its supernatant to test their pathogenic activities. Oppositely, the avirulent strain did not develop any disease symptoms in either the cell or the supernatant, suggesting that the avirulent strain could be used safely for the biological administration of brown rot disease caused by the virulent strain.
The application of both forms of
R. solanacearum on potatoes shows that the physiological features of the plants in terms of total phenols and the defense-related enzymes (PPO, and POD) increased with all treatments, especially those of virulent treatments than the corresponding avirulent treatments. These results suggest that induced resistance was highly simulated in the plants infected with the virulent strain, and this may be due to the increment of plant defense with the increase in the threat of pathogens. Phenolics are secondary secretions with various roles in the mitigation of many abiotic and biotic stresses. Phenolic compounds have an antimicrobial action in plants, e.g., safeguarding against disease causatives such as microbes, weeds, nematodes, and others [
53,
54,
55]. Therefore, the infection by virulent
R. solanacearum and/or supernatant (boiled or non-boiled) led to an increase in biotic stress that led to increases in plant phenolic compound production as a response to such stress, compared with the avirulent strain. Furthermore, the phenolic compound may display antimicrobial and antioxidant activity that helps to evade pathogenic infections and induce resistance to protect the plant tissues from the toxic effect of reactive free radicals [
56,
57].
PPO and POD are defense-related enzymes, acting as biocontrol agents by increasing the immune response of the plant. This finding has previously been confirmed in three bacterial species (
Bacillus subtilis,
B. polymyxa, and
Pseudomonas fluorescens), which did not inhibit the growth of
R. solanacerum but induced systemic resistance by increasing phenolic compounds, peroxidase, PPO and POD [
58]. Another investigation stated that the phenolic compounds, peroxidase, PPO, and POD increased when bacterial wilt of potato was managed by the biocontrol agent Saccharomyces cerevisiae (cells and supernatant) without antagonizing
R. solanacerum [
17]. Therefore, the proposed application of the avirulent
R. solanacearum may biologically act as an inducer of plant defense.
The significant alteration occurred in potato growth due to the application of different virulent and virulent
R. solanacearum, of which virulent treatments significantly decreased the plant growth. Treatment with the avirulent strain of
R. solanacearum had a significant increase in plant height than other virulent treatments and the control. Similarly, the vaccination of the tomato plant leads to an increase in plant height by 13.71% [
14]. However, boiling and/or filtration such as in the case of BAV, SAV and SBAV led to an insignificant increase in plant height; this may be due to the reduction of the pathogenicity effectiveness of AV strain as a result of boiling and filtration. The number of branches showed insignificant alteration. As a response to potato growth promotion, a positive significant effect of avirulent and DCV treatments was recorded on LAI. The LAI is a significant sign of precipitation, radiation interception, energy conversion, and balance of water. Eventually, it is a reliable issue for plant growth and one of the main driving forces of nutrient, water usage, and carbon balance, consequently, on net production [
59]. Therefore, there was an obvious internment plant dry weight with the increments on LAI.
Pathologically, the virulent treatments increased the disease symptoms on potato plants compared to the avirulent treatments. This is an expected result since the pathogen and/or its secretions contain virulence factors such as components that cause pathogenicity and can suppress the plant defenses. Pathogens create proteins, called effectors, which go into the plant tissue to lower the defense response of plants, which enables the pathogen to succeed in infecting the host. These effectors can inhibit several metabolic or signaling pathways of the host response thus facilitating pathogen infection [
60]. Additionally,
R. solanacearum can metabolize ferulic acid and salicylic acid to protect itself from the toxic action of phenolic acids [
61]. Another protective mechanism of the metabolites and cells of the bioagents suggests the creation of reactive phytoalexins, phenolic compounds, and/or the formation of physical barriers such as adjustments of cell walls and cuticles or pathogenesis-related proteins by the induced plant [
62].
The significant decrease in disease caused by SAV treatment may be due to the SAV-containing components that play a role in the inhibition of virulent
R. solanacearum. While the insignificant decrease in wilt disease caused by BAV treatment may be due to the alteration of components of BAV by heat and a possible reaction between these components since the high temperature led to destroying the membrane and changing the chemical composition of the heat-treated treatments [
19].
The SV treatment had the highest value of wilt disease rate, which may be due to the presence of components that can cause disease and increase the symptoms of bacterial wilt disease and increase the dwarfing of the potato plants. The boiling, as aforementioned, can change the components of the supernatant and decrease the pathogenic effect of the SV treatment, therefore, the BV and SBV had less pathogenic effect than the SV. Additionally, DCV may have a pathogenic effect on the potato plant but less than the supernatant (boiled and non-boiled).
At the end of the experiment, the avirulent treatments significantly surpassed other treatments in the productivity of potatoes and significantly decreased the infected tubers with brown rot. Plant tissues with high intensity of avirulent
R. solanacearum banned or hindered the entry of the virulent pathogen since the avirulent strain of
R. solanacearum can invade and enter the plant host and occupy all space without injury to the root, hindering and delaying the multiplication of the virulent strain of
R. solanacearum [
9,
12]. Furthermore, the presence of avirulent
R. solanacearum increases the availability of soil nutrients by changing the soil conditions into neutral; the latter is one of the main factors for the management of bacterial wilt disease [
13]. These effects may be due to phytohormones and other substances secreted by the avirulent strain of
R. solanacearum that act like bioagents in encouraging plant growth and productivity, as well as decreasing bacterial wilt disease [
17,
58].
The increase in brown rot disease of potato tubers and decrease in potato tubers productivity in virulent treatments may be due to the increase in exopolysaccharides that are the major virulence factor, causing wilting of the host plant due to plugging the plant vessels [
6] and an increase in enzymes and other components secreted by the virulent
R. solanacearum [
16,
60,
63]. Our results reveal no significant alteration in the tubers’ number at harvesting; however, there was some decay in the tubers, which reflected on the weight only, but none of them were totally decayed, therefore, there was no significant change in the tubers’ number. In contrast, a significant decrease in the percentage of latent infection of stored tubers was recorded by avirulent bacterial treatments.
The results of GC–MS analysis demonstrated that the fatty acids or their derivatives (fatty acid methyl esters and fatty acid ethyl esters) were detected in all types of cell-free culture supernatant of the virulent and avirulent strains of
R. solanacearum. Fatty acids are vital biomolecules that play a central role in almost all organisms and act as signaling means in plant–microbe interactions and are involved in important physiological functions in cells. For instance, several studies have revealed that palmitic acid, a saturated long-chain fatty acid compound, has shown remarkable antibacterial properties towards Gram-positive and Gram-negative bacteria [
64] as well as inhibition of the growth of the plant pathogenic fungi and promoting the growth of seedlings [
65,
66]. The mechanisms of antimicrobial action by palmitic acid are related to increasing cellular toxicity and the rate of cell death with reduced ergosterol content in the plasma membrane by inducing reactive oxygen species (ROS). The building up of ROS causes severe damage to cellular DNA, RNA, and protein levels as well as alters the virulence processes of the cell [
67].
The compound 4H-Pyran-4-one, 2,3-dihydro-3,5-dihydroxy-6-methyl- = 2,3-dihydro-3,5-dihydroxy-6-methyl-4H-pyran-4-one (DDMP) was found in all cell-free supernatants except the avirulent strain supernatant. This compound is one of the primary bitter compounds that was identified to be generated in the intermediate stage of the Maillard reaction and its formation is related to sugars (fructose, and glucose), amino acids (tyrosine, proline, histidine, and lysine) [
68]. The toxicological relevance of DDMP is not clear, but it is thought to generate free radicals that damage DNA through self-oxidation, another DDMP that has a strong antioxidant effect and other activities [
69].
In general, the antimicrobial activity of the avirulent supernatant may be owing to the major constituents or the collaborative effects between the minor and major components [
70]. The efficacy of the combination exceeds the predictable cumulative efficacy of the separate component alone.
It is noticeable that the boiling process results in a difference in the activity and composition of the supernatant of both the virulent and avirulent strains of
R. solanacearum. It is possible that the boiling process leads to the breaking of some compounds and/or a reaction between different components present in the bacterial supernatant, or may cause damage and breakdown of extracellular polysaccharides of the virulent strain, leading to the loss of virulence. Furthermore, the boiling process enhances the total phenolic content, and antioxidant activities due to the liberation of bound phenolic substances and the creation of intermediate generated owing to the Maillard reaction products and decreased the content of individual functional components owing to their thermal decomposition. Another reason is the elevated sugar content and reduced total free phenols and fatty acids [
71]. All these changes in components in the boiled supernatants led to a change in their effects on the plant in this investigation.
It is worth mentioning the reversal possibility of the avirulent strain to the virulent strain type [
6,
18]. That possible reversion represents a limitation for the wide application of the avirulent strain. Our paper, therefore, suggests an innovative simple application through using thermal treatment (boiling) or cell-free supernatant to simply overcome this possible reversion problem and gave alternative forms of the avirulent
R. solanacearum to manage the bacterial wilt of potatoes and other plants. What is more, this method can be generalized to manage bacterial diseases in plants, animals, and human beings, which may be useful tools for biological control.